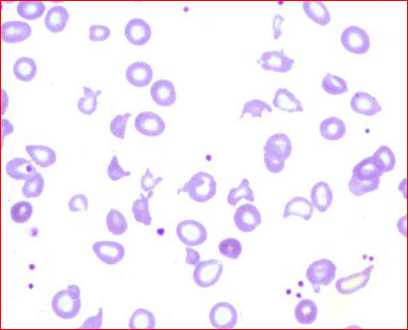

secondary vs primary HTN
-secondary: 5-10%; with some identified underlying disease most often renal or adrenal -primary: 90-95%; no identified underlying single cause; probably multigene controlled plus environment
Benign vs Malignant HTN
-benign: 95%; diastolic>90 or systolic >140; clinically silent until late in the course -malignant: 5% usually follows benign HTN after 8 years but can rarely be de novo; diastolic >120, systolic >210; likely clinically symptomatic; LETHAL if not treated rapidly and adequately; usually in patients with secondary HTN
Vascular changes in HTN that are not unique to HTN
-acceleration of other vascular diseases like atherosclerosis, hyalin arteriolosclerosis; seen with any HTN
Vascular changes unique to HTN
-1. adaptive: vasoconstriction of arterioles, medial hypertrophy of large/medium arteries, fibroelastic intimal hyperplasia of small arteries; seen with any HTN 2. destructive: fibrinoid necrosis, hyperplastic arteriolitis (concentric proliferation of SMCs and interstitial PGs), microangiopathic hemolytic anemia; SEEN WITH MALIGNANT HTN ONLY!

fatty streaks in aorta (the early lesion of atherosclerosis)

hyaline arteriolosclerosis (within kidney)

intimal fibroelastic hyperplasia in small renal artery
Examples of reversible vs irreversible changes in vascular resistance and what the consequences are
- function and some structural changes are reversible: vasoconstriction, medial hypertrophy
- some structural changes are irreversible: arterial fibroelastic intimal hyperplasia, hyalin arteriolosclerosis, advanced atherosclerosis
- irreversible changes lead to a fixed increase in vascular resistance, making rx more difficult
3 destructive changes of malignant HTN
- fibrinoid necrosis
- hyperplastic intimal arteriolitis
- microangiopathic hemolytic anemia
- all of these occuring in arterioles

fibrinoid necrosis in malignant HTN; a destructive change occuring due to deposition of fibrin and other plasma proteins in the walls of arterioles, associated with the necrosis of endothelial cells and medial smooth muscle
-top arrow is fibrinoid necrosis; bottom is lumen

hyperplastic intimal arteriolitis (destructive changes in malignant HTN): concentric proliferation of SMCs and interstitial PG deposition in small arteries and arterioles
- onion skinning appearance
- due to healing of fibrinoid necrosis acute lesions and probably driven by PDGF
Microangiopathic Hemolytic anemia (MAHA): shearing off of red cell fragments resulting in schistocytes by passage through fibrin mesh at increased pressures within the lumen of arterioles
Clinical manifestations of benign HTN :The silent killer
- benign HTN is silent until…
1. CHF
2. MI
3. Stroke
4. chronic renal failure
5. subsequent malignant HTN
Cardiac lesions due to effects of HTN
-concentric LVH, accelerated coronary atherosclerosis (leading to angina, MI, CHF): increased demand but decreased O2 supply
Renal lesions due to effects of HTN
-nephroarteriolosclerosis= microvascular disease with glomerlar scarring and tubular atrophy –> chronic renal failure
cerebral effects due to HTN
-microaneurysms ( –> intracerebral hemorrhage), lacunae, rupture of berry aneurysm (SAH), accelerated atherosclerosis leading to possible ischemic infarction

hypertrophied myocytes in HTN
3 effects of cLVH
- increased myofibrils, increases energy requirements, less efficient function
- as myocardial arteries compromised, decreased peak myocardial blood flow leading to ischemia, atrophy, fibrosis
- decreased compliance of LV with impaired diastolic filling and impaired systolic contractility

hyaline arteriolosclerosis with glomerular sclerosis and tubular atrophy due to HTN
-benign nephrosclerosis
5 components of renal benign nephrosclerosis
- bilateral symmetrical moderate decrease in size with decrease in cortical thickness
- granular surface
- vascular changes: hyaline arteriolosclerosis
- gradual fibrosis replacement of glomeruli (glomerulosclerosis) and associated tubular atrophy due to chronic ischemia
- possible progression to chronic renal failure
Nephroarteriolosclerosis is a microvascular disease with glomerular scarring and tubular atrophy which can lead to chronic renal failure. What are effects of this process that make HTN even worse?
- decreased GFR and decreased Na secretion
- activation of RAAS
- loss of urodilatin *or some naturetic factor of renal origin)
- general loss of renal excretory function to produce chronic renal failure

microaneurysms in retina due to HTN
Who gets malignant hypertension?
- usually preceded by benign HTN for avg of 8 years
- 35-50 years old
- more frequent in men, smokers, AAs, pts of lower SES
Mortality of malignant HTN if treated vs untreated
- 90% mortality within 1 year if untreated
- 75% 5 year survival if treated properly













